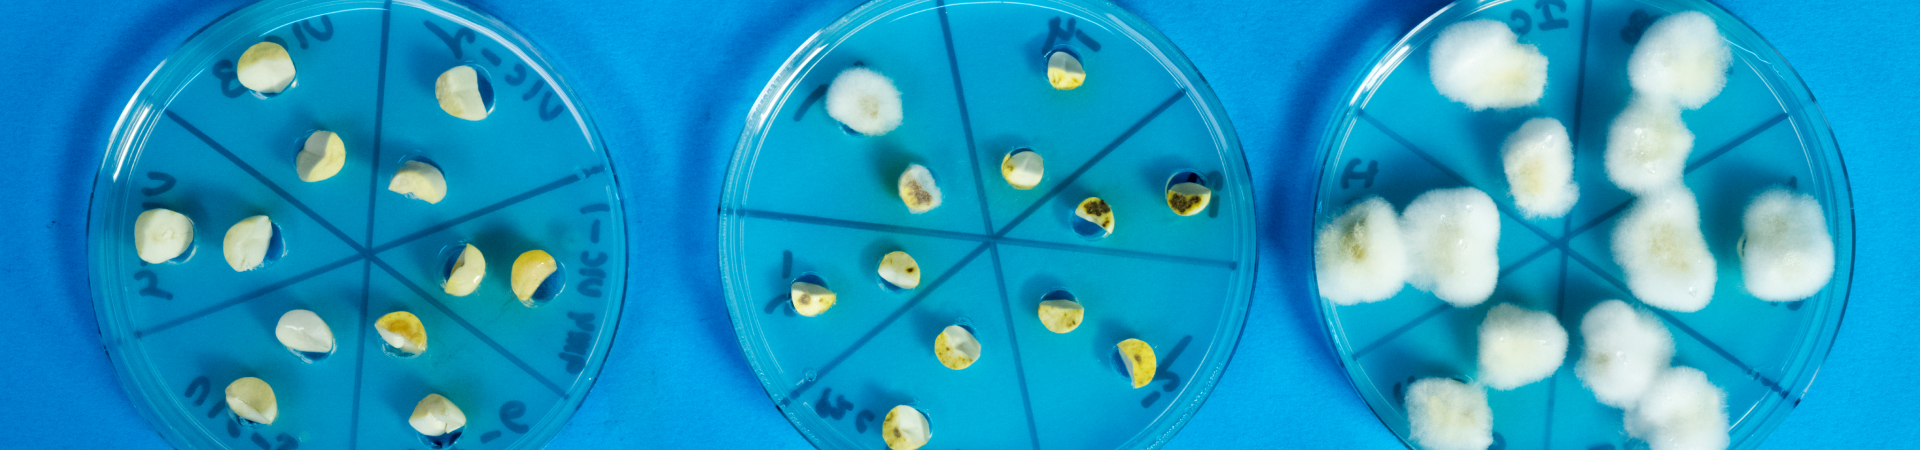

We are dedicated to ensuring the safety and quality of food products through comprehensive testing and analysis, with a particular focus on aflatoxin contamination.
Food safety is a critical concern for both consumers and the agricultural industry and we recognize the detrimental impact of aflatoxins, harmful toxins produced by certain molds, on human health and trade. Our Food Safety and Aflatoxin Testing Services provide accurate and reliable assessments to help mitigate risks associated with aflatoxin contamination and ensure the production and consumption of safe and high-quality food.
Our team of experts utilizes state-of-the-art laboratory facilities, advanced testing methodologies, and internationally recognized protocols to detect and quantify aflatoxins in a wide range of food and feed samples. By employing rigorous quality control measures and adhering to strict standards, we deliver precise results that meet regulatory requirements and industry benchmarks.
In addition to aflatoxin testing, we offer comprehensive food safety analysis services to evaluate other quality parameters, such as mycotoxins, pesticide residues, heavy metals, microbiological contaminants, and more. Our holistic approach ensures that all aspects of food safety are addressed, providing stakeholders with a comprehensive understanding of the safety and quality of their food products. We also provide access to resources, guidelines, and expert support to help you navigate the complexities of food safety regulations and implement effective control measures.
Should you have any questions or require further assistance, our dedicated support team is ready to help. Please email: icrisat-research@icrisat.org
A
Agribusiness and Innovation Platform
B
C
Crop Protection and Seed Health
Cell, Molecular Biology and Genetic Engineering
Climate Adaptation and Mitigation
D
E
Enabling Systems Transformation
F
G
Genomics, Pre-Breeding and Bioinformatics
GeoSpatial and Big Data Sciences
I
K
Knowledge and Capacity Development
L
Landscapes, Soil Fertility and Water Management
Legal and Intellectual Property
M
Markets, Institutions and Policies
N
